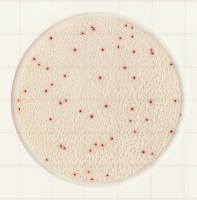

2014年9月18日
微生物検査用フィルム培地『Medi・Ca®(メディカ)』3種を発売
簡単な操作で作業効率が向上し、検査業務の負荷を大幅に削減
大日本印刷株式会社(本社:東京 社長:北島義俊 資本金:1,144億円 以下:DNP)は、食品・飲料メーカーなどが品質管理で実施している微生物検査業務の効率を改善するフィルム型の培地キット『Medi・Ca』の販売を9月に開始します。この培地キット『Medi・Ca』は、微生物の培養に必要な栄養成分などをシート状のフィルムにコーティングしており、従来のシャーレを使用した培地に比べ、取り扱いが簡単で、確実かつ効率的に検査作業を進めることができます。
今回発売するのは、一般生菌数測定用のAC(Aerobic Count)グレード、大腸菌群数測定用のCC(ColiformCount)グレード、大腸菌・大腸菌群数測定用のEC(E.coli, coliform Count)グレードの3種類です。
左(赤):ACグレード、中(青):CCグレード、 右(緑):ECグレード
【発売の背景】
“食の安全・安心”を維持するため、食品メーカーにおける微生物検査の重要性が高まっており、検査の件数や頻度も増加しています。微生物検査の多くは、寒天などで固形化した栄養成分を充填したシャーレで培養された菌を検査する寒天培地で行われています。寒天培地は、粉末状の栄養素と寒天を正確に計量し、溶かした後に滅菌して、寒天が固形化するまでに数時間定温で保持するなどの「前処理」が必要で、検査の増加に比例して増大する前処理作業の負荷が課題となっています。また、検査後のシャーレ等は滅菌して廃棄する必要があり、検査業務全体の負荷軽減や廃棄物の削減につながる検査手法が求められていました。
このニーズに対してDNPは、2010年に開発したMedi・Caが、微生物検査業務の効率化や廃棄物の減容化に最適であるとして、このたび本格的に販売を開始することとしました。
【Medi・Caの概要と特長】
Medi・Caは、寒天に代わるゲル化剤と栄養素などをシート状のフィルムにコーティングすることで、寒天培地のような前処理作業を不要としました。作業者のコツや熟練を要する寒天培地とは異なり、取り扱いが簡単で、確実かつ効率的な検査業務を実現します。
簡単で扱いやすく、すぐに使える調製済み培地
前処理不要の調製済み培地のため、外装のアルミ袋から取り出してすぐに使用でき、緊急の検査などにも迅速に対応できます。また、検査する食品などを希釈した試料液を培養エリアの中央に滴下し、カバーフィルムを閉じるだけで試料液が培養エリア全体に広がってゲル化するため、効率的に作業を進めることができます。

コロニーが見やすく、カウントしやすい
各グレードには、発色剤を使用しているため、培養後、微小な菌の集合体であるコロニーの視認性が高く、また食品残渣との判別が容易なため、コロニー数の計測をスピーディかつ確実に行えます。さらにACグレードはBacillus属による発色の滲みが少ないのも特長です。
省スペース化と廃棄量削減を実現
Medi・Caの容積はシャーレの約20分の1以下に減容化しているため、在庫や培養に要するスペースを削減し、使用後の廃棄物量を約20分の1程度に減らすことができます。また、滴下時にMedi・Caを重ねながら作業が行えるため、作業エリアの省スペース化が実現できます。

【参考価格と売上目標】
一般生菌数測定用ACグレード:1枚あたり75円
※価格は税別です。
DNPは、食品・飲料・菓子メーカー、飲食チェーン店などを中心に本製品を販売し、今後3年間の累計で5億円の売上を目指します。また、今年度中に、黄色ブドウ球菌のSA(Staphylococcusaureus)グレードを開発し、販売していく計画です。
開発中の案件について
現在、コロニー計測の業務負荷をより一層低減すべく、専用スキャナーを使ってコロニー数をリアルタイムで自動カウントするともに、画像と計測結果の保存を可能としたシステムを開発中です。
※ニュースリリースに記載された製品の価格、仕様、サービス内容などは発表日現在のものです。その後予告なしに変更されることがありますので、あらかじめご了承下さい。
※弊社「 DNP微生物検査用フィルム培地 Medi・ca」は、2021年3月31日をもちまして、キッコーマン株式会社に譲渡することになりました。2021年4月1日以降は譲渡した事業につきまして、キッコーマン株式会社のグループ会社であるキッコーマンバイオケミファ株式会社で「微生物検査用フィルム培地 Easy Plate」として引き続き販売されますので、ご愛顧のほどお願い致します。
- X(旧Twitter)にポスト(別ウインドウで開く)
- メール
- URLをコピー
- 印刷